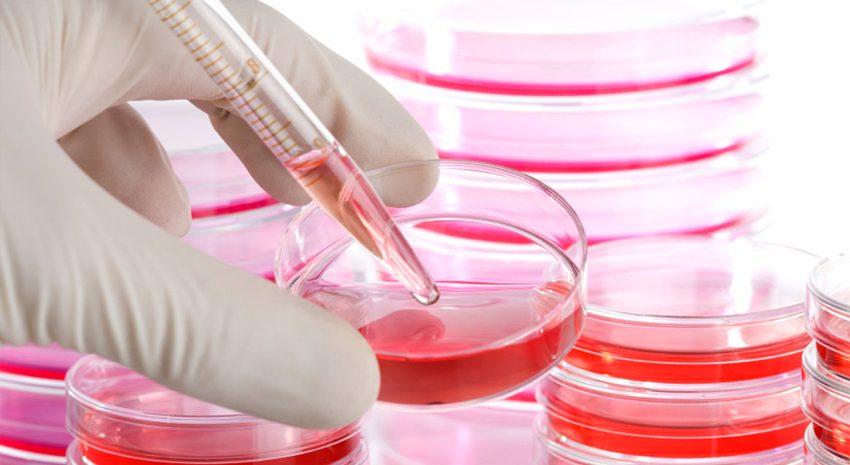

Per chi ha già avuto un infarto o un ictus la combinazione tra l’uso...
Il seguente pannello ti consente di esprimere le tue preferenze di consenso alle tecnologie di tracciamento che adottiamo per offrire le funzionalità e svolgere le attività sotto descritte. Per ottenere ulteriori informazioni in merito all'utilità e al funzionamento di tali strumenti di tracciamento, fai riferimento alla cookie policy. Puoi rivedere e modificare le tue scelte in qualsiasi momento